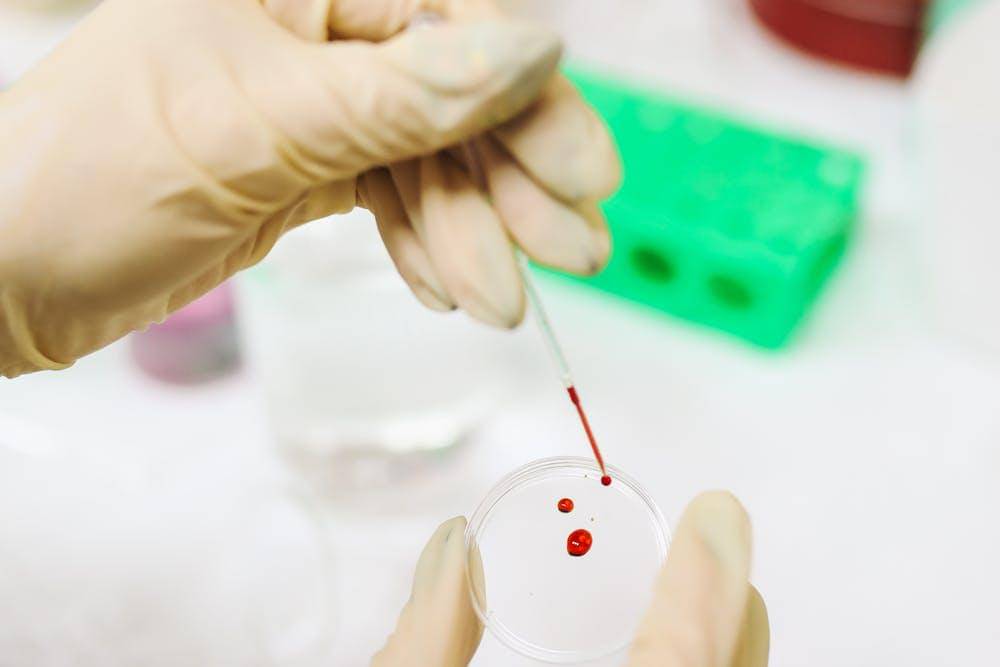
Pexels/Polina Tankilevitch

“Biasanya 72 jam itu batasnya. Kalau dalam waktu itu demamnya belum turun dan tanpa gejala berbahaya lainnya, kita bisa menunggu sampai 72 jam. Kalau lebih dari 72 jam, baru bisa pertimbangkan cek lab sederhana untuk membedakan virus atau bakteri,” ungkapnya.
Anak Demam, Kapan Harus Cek Darah? Ini Penjelasan Dokter

Demam pada bayi sering membuat orangtua khawatir, apalagi jika usianya masih di bawah 1 tahun. Kondisi ini memang bisa disebabkan oleh banyak hal, mulai dari infeksi ringan hingga penyakit yang memerlukan pemeriksaan lebih lanjut.
Salah satu langkah yang biasa disarankan dokter adalah cek darah untuk mengetahui penyebab pasti demam yang dialami si kecil. Namun, pertanyaannya, anak demam, kapan harus cek darah?
Jangan khawatir, di bawah ini Popmama.com telah merangkum penjelasannya dari dr. Lucky Yogasatria Sp.A, seperti yang dikutip dari Instagram pribadinya, @dr.lucky.sp.a.
1. Anak demam, kapan harus cek darah? Ini penjelasan dokter

dr. Lucky memahami mungkin orangtua panik ketika anaknya demam. Namun, cek darah lebih bijak sebaiknya menunggu selama 72 jam atau 3 hari terlebih dahulu. Menurut dr. Lucky, demam pada anak umumnya terjadi karena infeksi virus.
Selama 72 jam, imun tubuh anak akan berusaha melawan virus yang ada di dalam tubuh. Demam adalah tandanya, sehingga jika tidak ada gejala berbahaya, orangtua bisa menunggu proses ini.
2. Cek darah sebenarnya bisa saja dilakukan dari hari pertama, tapi...

dr. Lucky menjelaskan mengenai pemeriksaan darah saat anak demam. Secara umum memang pemeriksaan lab seperti ini bisa dilakukan kapan pun, baik di hari pertama, kedua, atau ketiga anak demam.
Namun, dr. Lucky mengingatkan orangtua soal tujuan dari cek darah tersebut.
“Bisa hari kedua, ketiga, bahkan baru demam langsung cek lab, itu bisa saja. Tapi kita lihat dulu tujuannya apa. Cek darah pada anak demam itu untuk mencari penyebab demamnya, bisa viru atau infeksinya,” jelas dr. Lucky.
Lebih lanjut lagi, dr. Lucky menyebut umumnya penyebab demam pada anak adalah infeksi virus yang akan sembuh sendiri saat daya tahan tubuh mengalahkan infeksi.
3. Cek darah terlalu dini bisa membuat hasilnya belum akurat
Meski cek darah di hari pertama anak demam memungkinkan, hasil pemeriksaan biasa belum tentu dapat membedakan infeksi virus atau bakteri. Namun, risikonya tidak bisa cek darah sederhana.
Karena pada masa awal infeksi, cek lab sederhana hasilnya belum menentu. Jika anak hanya demam saja tanpa gejala berbahaya lebih bijak menunggu 72 jam atau 3 hari.
“Kalau mau cek PCR, tubex, dengue, atau kultur, itu bisa hari pertama. Tapi permasalahannya, tidak semua lab bisa dan biayanya lebih mahal. Jadi, kalau tidak ada tanda bahaya dan hanya demam, sebaiknya tunggu 72 jam dan konsultasi dengan dokter anak,” saran dr. Lucky.
dr. Lucky juga mengingatkan sebaiknya tidak atas saran sendiri cek darah. Karena lebih baik konsultasikan ke dokter anak. Jika demam si kecil berlangsung lebih dari 72 jam, Mama dan Papa bisa ke dokter untuk memeriksa lebih lanjut.
4. Cek darah terlalu dini juga bisa membuat anak harus kembali menjalani tes darah di hari selanjutnya

Cek darah anak secara mandiri memang memiliki keuntungan, misalnya proses yang lebih cepat sehingga dokter dapat langsung menegakkan diagnosis berdasarkan hasil tersebut. Namun, hal ini bisa menjadi tidak efektif atau bahkan merugikan jika jenis pemeriksaan yang dilakukan tidak tepat atau tidak lengkap.
Misalnya, orangtua memeriksakan “darah rutin” padahal dokter membutuhkan “darah lengkap”, atau meminta uji Widal dan serologi demam dengue yang sebenarnya tidak relevan.
Risiko lainnya adalah pemeriksaan darah yang dilakukan terlalu dini, seperti pada demam baru 1–2 hari, yang umumnya belum memberikan informasi bermanfaat. Seperti yang disarankan oleh dr. Lucky, sebaiknya menunggu 72 jam atau 3 hari terlebih dahulu.
Ketika terlalu dini, anak mungkin harus kembali menjalani tes darah sehingga menambah biaya, dan mengalami tusukan jarum dua kali. Pemeriksaan laboratorium seperti cek darah memang penting, tetapi harus tepat jenis dan waktunya. Karena itu, sebaiknya anak diperiksa dulu oleh dokter yang memahami kondisi dan riwayat sakitnya.
Itulah tadi informasi mengenai kapan anak harus cek darah saat demam. Semoga membantu Mama dan Papa!



















